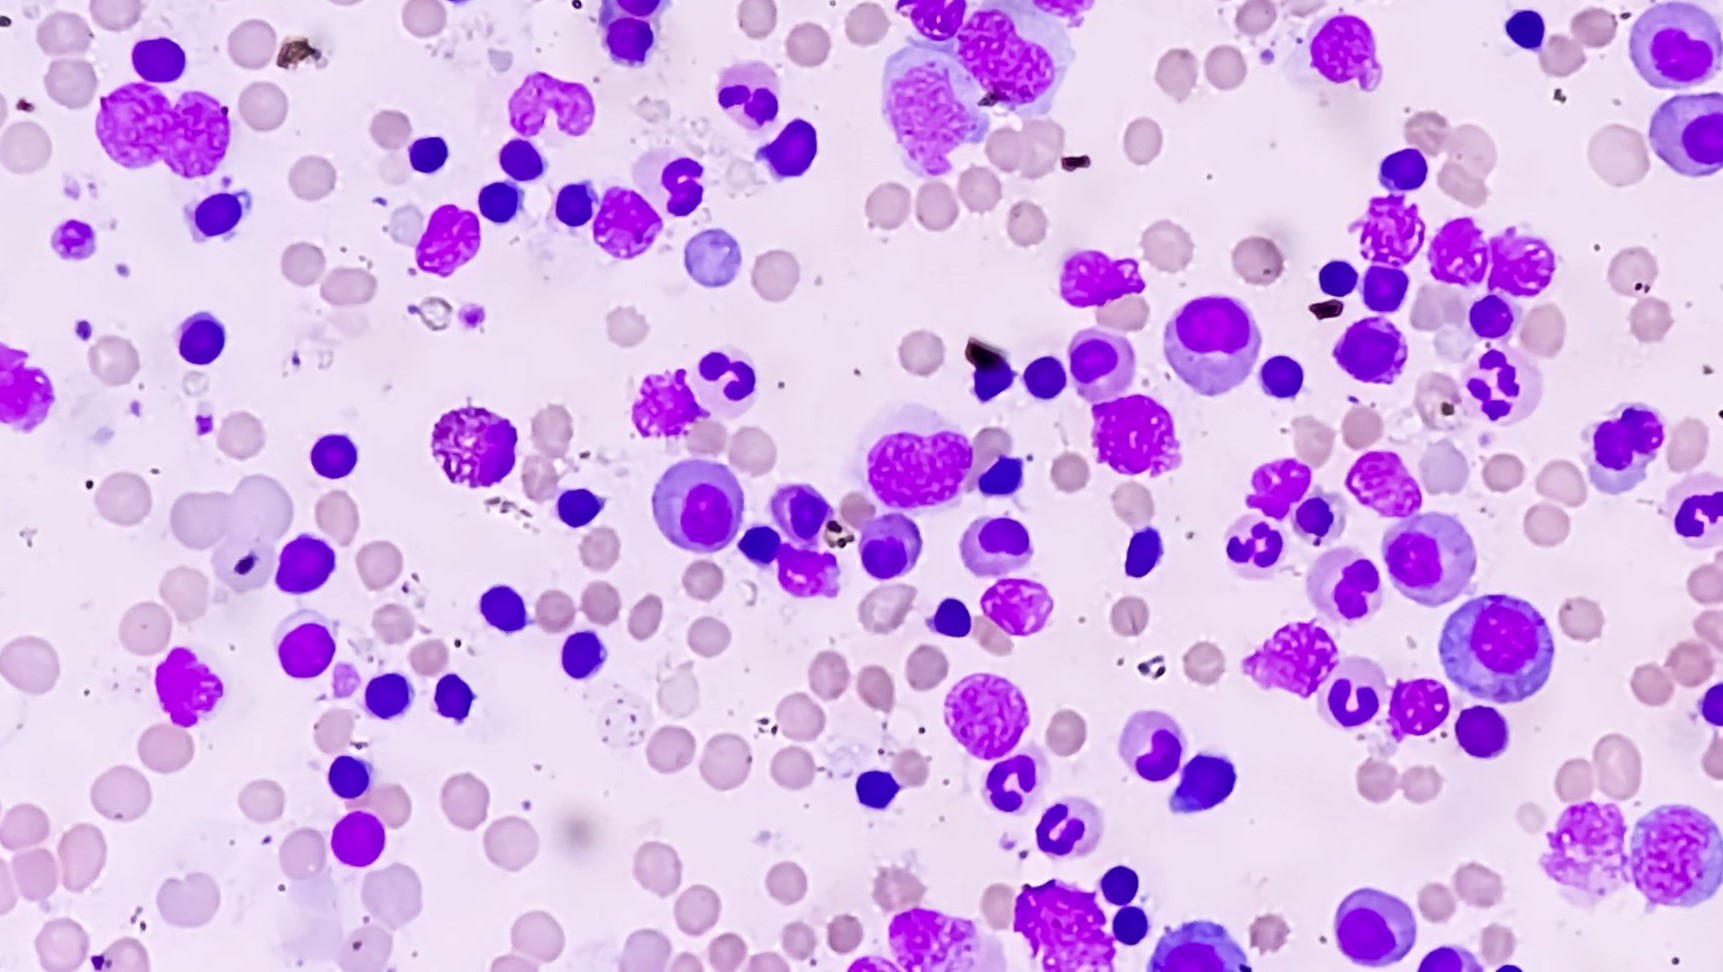

„Pokud chceme pomáhat pacientům, musíme se dlouhodobě věnovat výzkumu, ale také získané poznatky dotáhnout do klinické studie a k pacientům,“ říká hematolog a vědec Tomáš Stopka. S kolegy a kolegyněmi z centra BIOCEV, 1. lékařské fakulty Univerzity Karlovy a Všeobecné fakultní nemocnice v Praze (VFN) úspěšně dokončili klinickou studii nové kombinace léčiv, která výrazně prodlužuje život pacientů s leukémií.

Hematolog Tomáš Stopka ve své práci kombinuje péči o pacienty a základní výzkum.
„Je to zasloužený pocit něčeho dokončeného po letech vědecké i klinické práce, z níž máme obrovskou radost. To hlavní ale je, že tento náš drobný výsledek pomáhá pacientům – navozuje léčebné odpovědi a prodlužuje jejich život,“ říká o dokončené klinické studii profesor Stopka, vedoucí Laboratoře hematoonkologie a kmenových buněk na 1. lékařské fakultě UK v centru BIOCEV a hematolog-specialista ve VFN na Karlově náměstí.
Šest let práce k prestižní publikaci
Tým vědců a lékařů v klinické studii během více než šesti let ověřoval nový přístup v léčbě pacientů a pacientek s rizikovým myelodysplastickým syndromem (MDS) – nemoci krve, která přechází do akutní myeloidní leukémie (AML). „Nový klinický přístup je inovativní v tom, že ke standardnímu léku přidává lék další, a v kombinaci těchto dvou léčiv došlo k synergii, jež ovlivnila přežití pacientů,“ vysvětluje Stopka. Výsledky studie publikoval prestižní časopis Blood Cancer Journal z Nature Publishing Group.
|
Myelodysplastický syndrom (MDS) je onkologické onemocnění kostní dřeně, při kterém dochází ke snížené produkci nefunkčních krevních buněk. Kvůli tomu pak mají pacienti a pacientky nedostatek červených a bílých krvinek, které jsou klíčové pro obranyschopnost organismu, a také destiček pro krevní srážení. Pacienty s touto chudokrevností pak trápí anemie, z ní vycházející dušnost a únava, častá krvácení a jsou též méně odolní proti bakteriálním a virovým infekcím, například zápalu plic. Podle závažnosti onemocnění probíhá zpočátku podpůrná léčba pomocí antibiotik či opakovanou krevní transfúzí. Ve výjimečných případech lze pacienty léčit transplantací kostní dřeně. V Evropě jsou ročně diagnostikováni čtyři pacienti na 100 tisíc osob. V České republice registruje Všeobecná fakultní nemocnice přibližně až osmdesát pacientů ročně. Kritickou fází onemocnění MDS je přechod do akutní myeloidní leukémie (AML), vyznačující se velmi krátkým přežitím, což vyžaduje okamžité zahájení komplexní terapie. |
Myelodysplastický syndrom (MDS) je onkologické onemocnění kostní dřeně, při kterém dochází k produkci nefunkčních krevních buněk.
Dosavadní celosvětová léčba pacientů s MDS v přechodu do AML je postavena na podávání léku 5-Azacytidin, který byl vynalezen v 70. letech minulého století v Akademii věd ČR. Azacytidin je inhibitorem jaderných enzymů takzvaných DNA metyláz, které modifikují genom, což má u MDS klíčový význam. Genom je takovou knihovnou a bílkoviny, které ji modifikují, vlastně označují jednotlivé informace k použití. V případě MDS dochází k mutacím v genech ovlivňující DNA metylaci, a to vede k narušení chodu knihovny. „A právě na tyto poškozené enzymy cílí azacytidin,“ vysvětluje hematolog.
„Naše skupina na základě předchozích výzkumů, z nichž řada byla publikovaná v renomovaných časopisech, přišla s konceptem takzvané ‚diferenciační terapie pro MDS‘. Navrhli jsme před léčbou s azacytidinem ovlivnit genetický program kmenových buněk a toho jsme dosáhli s další látkou, cytokinem G-CSF, který podporuje vznik a vývoj bílých krvinek v kostní dřeni. Nejen že se nám podařilo prokázat léčebné účinky takového přístupu, ale zároveň jsme ukázali, že je bezpečný pro pacienty, ale především dokáže zvýšit počet léčebných odpovědí a prodloužit přežití v řádu měsíců,“ popisuje Stopka.
„Význam vidím v tom, že pacienti s klinickou léčebnou odpovědí mají mnohem lepší kvalitu života, méně ambulantních kontrol či transfúzí,“ dodává profesor.
Efektivnější léčba. I díky 76 dobrovolníkům
„Námi navržená léčebná kombinace činí léčbu efektivnější a bezpečnější pro pacienty a na základě realizované klinické studie představuje ověřenou strategii, jež je okamžitě použitelná v praxi. Těchto výsledků bychom nedosáhli nebýt obrovské ochoty 76 pacientů, kteří se do studie dobrovolně zapojili,“ zdůrazňuje Anna Jonášová z I. interní kliniky – kliniky hematologie 1. LF UK a VFN.
Studie slaví úspěch i mezi odborníky. „Dostáváme ohlasy od kolegů z celého světa – zajímají se o další podrobnosti a konzultují léčebný protokol. Velkou radost nám udělal například dopis od profesora Petera L. Greenberga ze Stanford University, nestora našeho oboru, který vytvořil diagnostické skóre pro riziko přechodu MDS do leukémie, a to je v našem oboru naprosto klíčová věc. Napsal nám, že o roli cytokinu G-CSF přemýšlel již před dvaceti lety a že je z našeho výzkumu nadšený,“ sdílí Tomáš Stopka.
Nechtěli jsme jen čekat
Jak to celé začalo? „Některé myšlenky se postupně rozvíjejí, ale těžko to lze dělat bez zkušeností se základním výzkumem. Po dokončení medicíny jsem deset let věnoval pouze základnímu výzkumu. Mimo jiné jsem pracoval v laboratoři profesora Josefa Prchala (s ním již před časem v UK Forum vyšel rozhovor – pozn. red.) na Alabama University v Birminghamu. Pepík mistrovsky spojuje medicínu a vědu – je klinický hematolog a vede laboratoř, kde nemoci zkoumá. Jeho přístup mě nesmírně inspiroval a byl i jedním z hlavních důvodů, proč jsem se rozhodl vrátit i do kliniky,“ vzpomíná Tomáš Stopka.
„Kolem roku 2010 bylo v oblasti myelodysplastického syndromu stále takové temné období, kdy nepřicházely nové léky, ale již se začalo blýskat na lepší časy. Hodně se zjistilo v oblastech patogeneze MDS a především mutací, ale stále chyběly jakékoli nové možnosti léčby. Všichni v oboru se pokoušeli o léčebné kombinace s azacytidinem a ani my jseme nechtěli jen tak čekat. Chtěli jsme využít naše zkušenosti ze základního výzkumu. V té době se ukázalo, že azacytidin v kombinaci s cytokinem G-CSF by mohl mít ještě lepší – synergický efekt. Současně jako náš článek vyšel i jiný o decitabinu, kde se tato hypotéza nezávisle potvrdila, ale stále to byly ‚jen‘ výsledky z laboratoře. A tak jsme v roce 2013 na klinice s kolegyní docentkou Jonášovou a dalšími začali dávat dohromady klinickou studii, kterou pak schválil Státní ústav pro kontrolu léčiv a od ledna 2015 mohla začít,“ popisuje Stopka.
Ačkoliv schvalovací proces trval dva roky, spolupráce se SÚKL byla podle něho korektní. „Byli velmi nápomocní a vstřícní, my jsme naopak se v oblasti akademických klinických studií museli leccos naučit,“ líčí.
Nadšení, šikovný tým a mravenčí práce
„Bez kvalitních, motivovaných a zapálených lidí by to nešlo. Zde určitě musím jmenovitě zmínit kolegy Lubomíra Minaříka, Ninu Dusilkovou nebo Helenu Poláčkovou, za cytogenetiku Zuzanu Zemanovou a Martu Kalousovou ze sekvenačního centra VFN, ale i další zdravotníky nemocnice. Kredit zaslouží určitě i statistik Michal Pešta z Matfyzu a též Vojtěch Kulvait jako bioinformatik. S ohledem na to, že jsme malý český tým lékařů a akademiků, se nám podařilo tento projekt dotáhnout do slušného výsledku. Je to zhodnocení velkého povětšinou dobrovolného úsilí a mravenčí práce,“ zdůrazňuje Stopka zásadní roli celého týmu.
„Jako čerstvý absolvent medicíny jsem se podílel především na hodnocení klinických dat a jejich zpracování a dále na sekvenování pacientských vzorků,“ říká Lubomír Minařík (na snímku), jenž s Tomášem Stopkou sdílí prvoautorství článku.
„MDS nepatřila donedávna mezi příliš perspektivní nemoci v hematologii a v tom je stále potřeba něco dělat. Sice se situace v posledních letech zlepšila – objevila se nová léčiva, ale stále je tu prostor pro další zlepšení a čím více nových možností léčby budeme moci nabídnout, tím lépe pro pacienty. MDS je bohužel velmi heterogenní onemocnění a počty pacientů pro správné klinické hodnocení musejí být dostatečně velké,“ dodává Minařík.
Pokračujeme... Bude trojkombinace lepší?
V současné době probíhají intenzivní jednání o nové celoevropské studii, ve které by se k 5-Azacytidinu za testování G-CSF přidal další lék s názvem Venetoclax, inhibitor proteinu BCL2, jež řídí přežívání nádorových buněk. „Nevíme, jak to bude přesně fungovat, i když určitou představu samozřejmě máme. U chemoterapií neplatí, že čím více léků použijete, tím bude lepší efekt – kumuluje se často toxicita účinků. K tomuto výzkumu ale máme připojeny také projekty základního výzkumu, a tudíž i případný negativní výsledek, zjištění, že nový postup nefunguje dle očekávání či funguje jinak, by byl velmi cenný a budeme vědět i proč to případně nefungovalo,“ říká Tomáš Stopka.
A dodává. „Jsem rád, že se nám v České republice daří úspěšně propojovat genetická a klinická data, a díky tomu určovat, jakým způsobem se bude MDS a AML léčit v brzké budoucnosti. Pokud chceme pro pacienty něco udělat, tak se musíme opravdu věnovat základnímu výzkumu a snažit se dotáhnout zajímavá zjištění ke klinickým studiím. Zároveň musíme motivovat pacienty, aby se jich zúčastnili. Není to jen o tom přinášet nové léky, ale především intenzívně zkoumat jejich účinek a přemýšlet i na úrovni jednoho pacienta! Pak teprve mohou vzniknout nové přístupy, které lze dále zkoumat ve studiích. K tomu je též zapotřebí vést vědeckou diskuzi na mezinárodní úrovni a pak teprve se posuneme o další krůček dál.“
